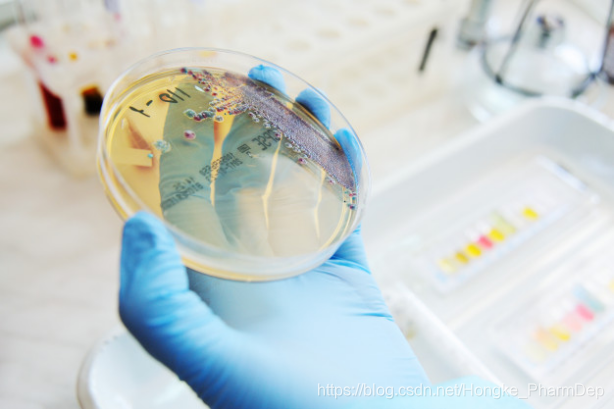

生物医疗低温运输及存储过程中的温度监测,广泛应用于药品流通企业、医院、药店、疾控中心、检测中心、生物制药公司、科研院所等机构,确保生物样本、药品、血液制品、疫苗、检测试剂的安全有效,为科学研究、疾病诊断或治疗,提供了强有力的保障。 生物样本安全: 对于国家级研究机构、高校、医药研发企业、第三方检测中心、医院等,生物样本由于需要在长时间存储中保存生物分子及细胞的活性,因此需要极低的存储温度,长期保存样本的存储要求达到-86℃、-150℃甚至-196℃,通过尽可能低的温度来降低样本内的生化反应,以提高样本内各种成分的稳定性;同时,长期存储过程中温度的稳定性及均匀性,也将对样本质量产生影响。其储品类型包括:细菌、细胞、骨髓、组织、核酸、病毒、受精卵、血浆、蛋白质、临床样品。其存储周期是由使用周期所决定的,存储周期相对较长,可达数年。无法达到并保持适合的温度,将直接导致生物样本的活性降低或失效,丧失其极高的研究价值或治疗价值。因此对于生物样本进行低温、超低温的温度监测是至关重要的。 药品及试剂安全: 对于药品生产、流通企业,医院、药店等,传统化学药品需要低温储存的品种比较少,主要包括部分抗菌注射用药、维生素类以及一些特殊剂型药品如栓剂等;生物药多由各类生物大分子组成,主要包括单克隆抗体、重组治疗性蛋白、细胞与基因治疗及其他生物疗法等品类,对低温储存需求较大,是目前药品领域低温存储的主要品种。其存储温度要求为2°C至8°C,药品周转量及保质期决定存储周期,通常为数月。对于检测试剂生产、流通企业,医院、第三方检验机构、药品研发及科研机构等,需要低温冷藏的检测试剂:基本所有涉及抗原、抗体、活性酶的检测试剂均需低温冷藏。其存储温度要求为2℃至 8℃,或-15℃以下,检测试剂周转量及保质期决定存储周期,通常为数月。 疫苗安全: 对于疫苗生产、流通企业,终端接种单位等,疫苗的存储和运输的温度要求为2°C至8°C;而弱毒活疫苗对温度的要求为-15°C以下。不同疫苗的有效期不同,通常为数月。疫苗对温度非常敏感温度过高或者过低都有失效的可能性。2019年12月1日正式实施《中华人民共和国疫苗管理法》明确对疫苗实行最严格管理制度,实行疫苗全程电子追溯制度,是为了加强疫苗管理,保证疫苗质量和供应,规范预防接种,促进疫苗行业发展,保障公众健康,维护公共卫生安全,制定的法律。 血液安全: 对于血站及医疗机构,全血、红细胞对温度的要求为2°C至6 ℃,含 ACD-B 的全血保存期为 21 天;含 CPDA-1的全血保存期 35 天。对于血浆站,血液制品企业及医疗机构,血浆对温度的要求为-18°C以下,存储周期自血液采集之日起 1 年。 实验室安全: 对于各类科研机构实验室、药企研发部门等,各类试剂及实验样本等根据储品类型不同,对温度的要求覆盖了-196℃至 8℃。其存储周期根据储品不同,其中试剂类一般较短,十几天至数个月,而样本类可能达到几年。

本网页所有视频内容由 imoviebox边看边下-网页视频下载, iurlBox网页地址收藏管理器 下载并得到。
ImovieBox网页视频下载器 下载地址: ImovieBox网页视频下载器-最新版本下载
本文章由: imapbox邮箱云存储,邮箱网盘,ImageBox 图片批量下载器,网页图片批量下载专家,网页图片批量下载器,获取到文章图片,imoviebox网页视频批量下载器,下载视频内容,为您提供.
阅读和此文章类似的: 全球云计算
官方软件产品操作指南 (170)